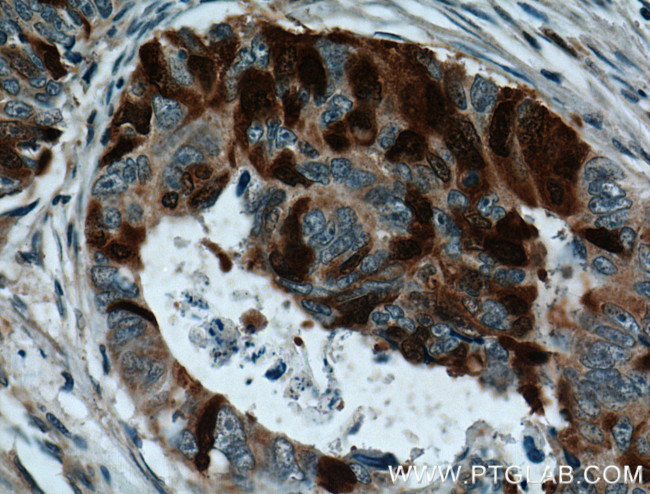
UBE2C Antibody in Immunohistochemistry (Paraffin) (IHC (P))

Search
Proteintech
UBE2C Polyclonal Antibody
{{$productOrderCtrl.translations['antibody.pdp.commerceCard.promotion.promotions']}}
{{$productOrderCtrl.translations['antibody.pdp.commerceCard.promotion.viewpromo']}}
{{$productOrderCtrl.translations['antibody.pdp.commerceCard.promotion.promocode']}}: {{promo.promoCode}} {{promo.promoTitle}} {{promo.promoDescription}}. {{$productOrderCtrl.translations['antibody.pdp.commerceCard.promotion.learnmore']}}





Please note: We are reviewing Western blot images included in the antibody testing data in our catalog, including those provided by third parties. Unless expressly labeled or annotated as “raw-unedited”, Western blot images included in the antibody testing data in our catalog may have been edited, optimized or otherwise adjusted for presentation.
产品信息
12134-2-AP
种属反应
已发表种属
宿主/亚型
分类
类型
抗原
偶联物
形式
浓度
规格
纯化类型
保存液
内含物
保存条件
运输条件
产品详细信息
Immunogen sequence: MASQNRDPA ATSVAAARKG AEPSGGAARG PVGKRLQQEL MTLMMSGDKG ISAFPESDNL FKWVGTIHGA AGTVYEDLRY KLSLEFPSGY PYNAPTVKFL TPCYHPNVDT QGNICLDILK EKWSALYDVR TILLSIQSLL GEPNIDSPLN THAAELWKNP TAFKKYLQET YSKQVTSQEP (1-179 aa encoded by BC016292)
靶标信息
This gene encodes a member of the E2 ubiquitin-conjugating enzyme family. The encoded protein is required for the destruction of mitotic cyclins and for cell cycle progression, and may be involved in cancer progression. Accepts ubiquitin from the E1 complex and catalyzes its covalent attachment to other proteins. In vitro catalyzes 'Lys-11'- and 'Lys-48'-linked polyubiquitination. Acts as an essential factor of the anaphase promoting complex/cyclosome (APC/C), a cell cycle-regulated ubiquitin ligase that controls progression through mitosis. Acts by initiating 'Lys-11'-linked polyubiquitin chains on APC/C substrates, leading to the degradation of APC/C substrates by the proteasome and promoting mitotic exit.
仅用于科研。不用于诊断过程。未经明确授权不得转售。
生物信息学
蛋白别名: (E3-independent) E2 ubiquitin-conjugating enzyme C; E2 ubiquitin-conjugating enzyme C; RP3-447F3.1; UbcH10; Ubiquitin carrier protein C; Ubiquitin-conjugating enzyme E2 C; Ubiquitin-protein ligase C
基因别名: 1110015A16Rik; D2Ertd695e; Ubch10; Ube2c
UniProt ID: (Mouse) Q9D1C1
Entrez Gene ID: (Rat) 296368, (Mouse) 68612